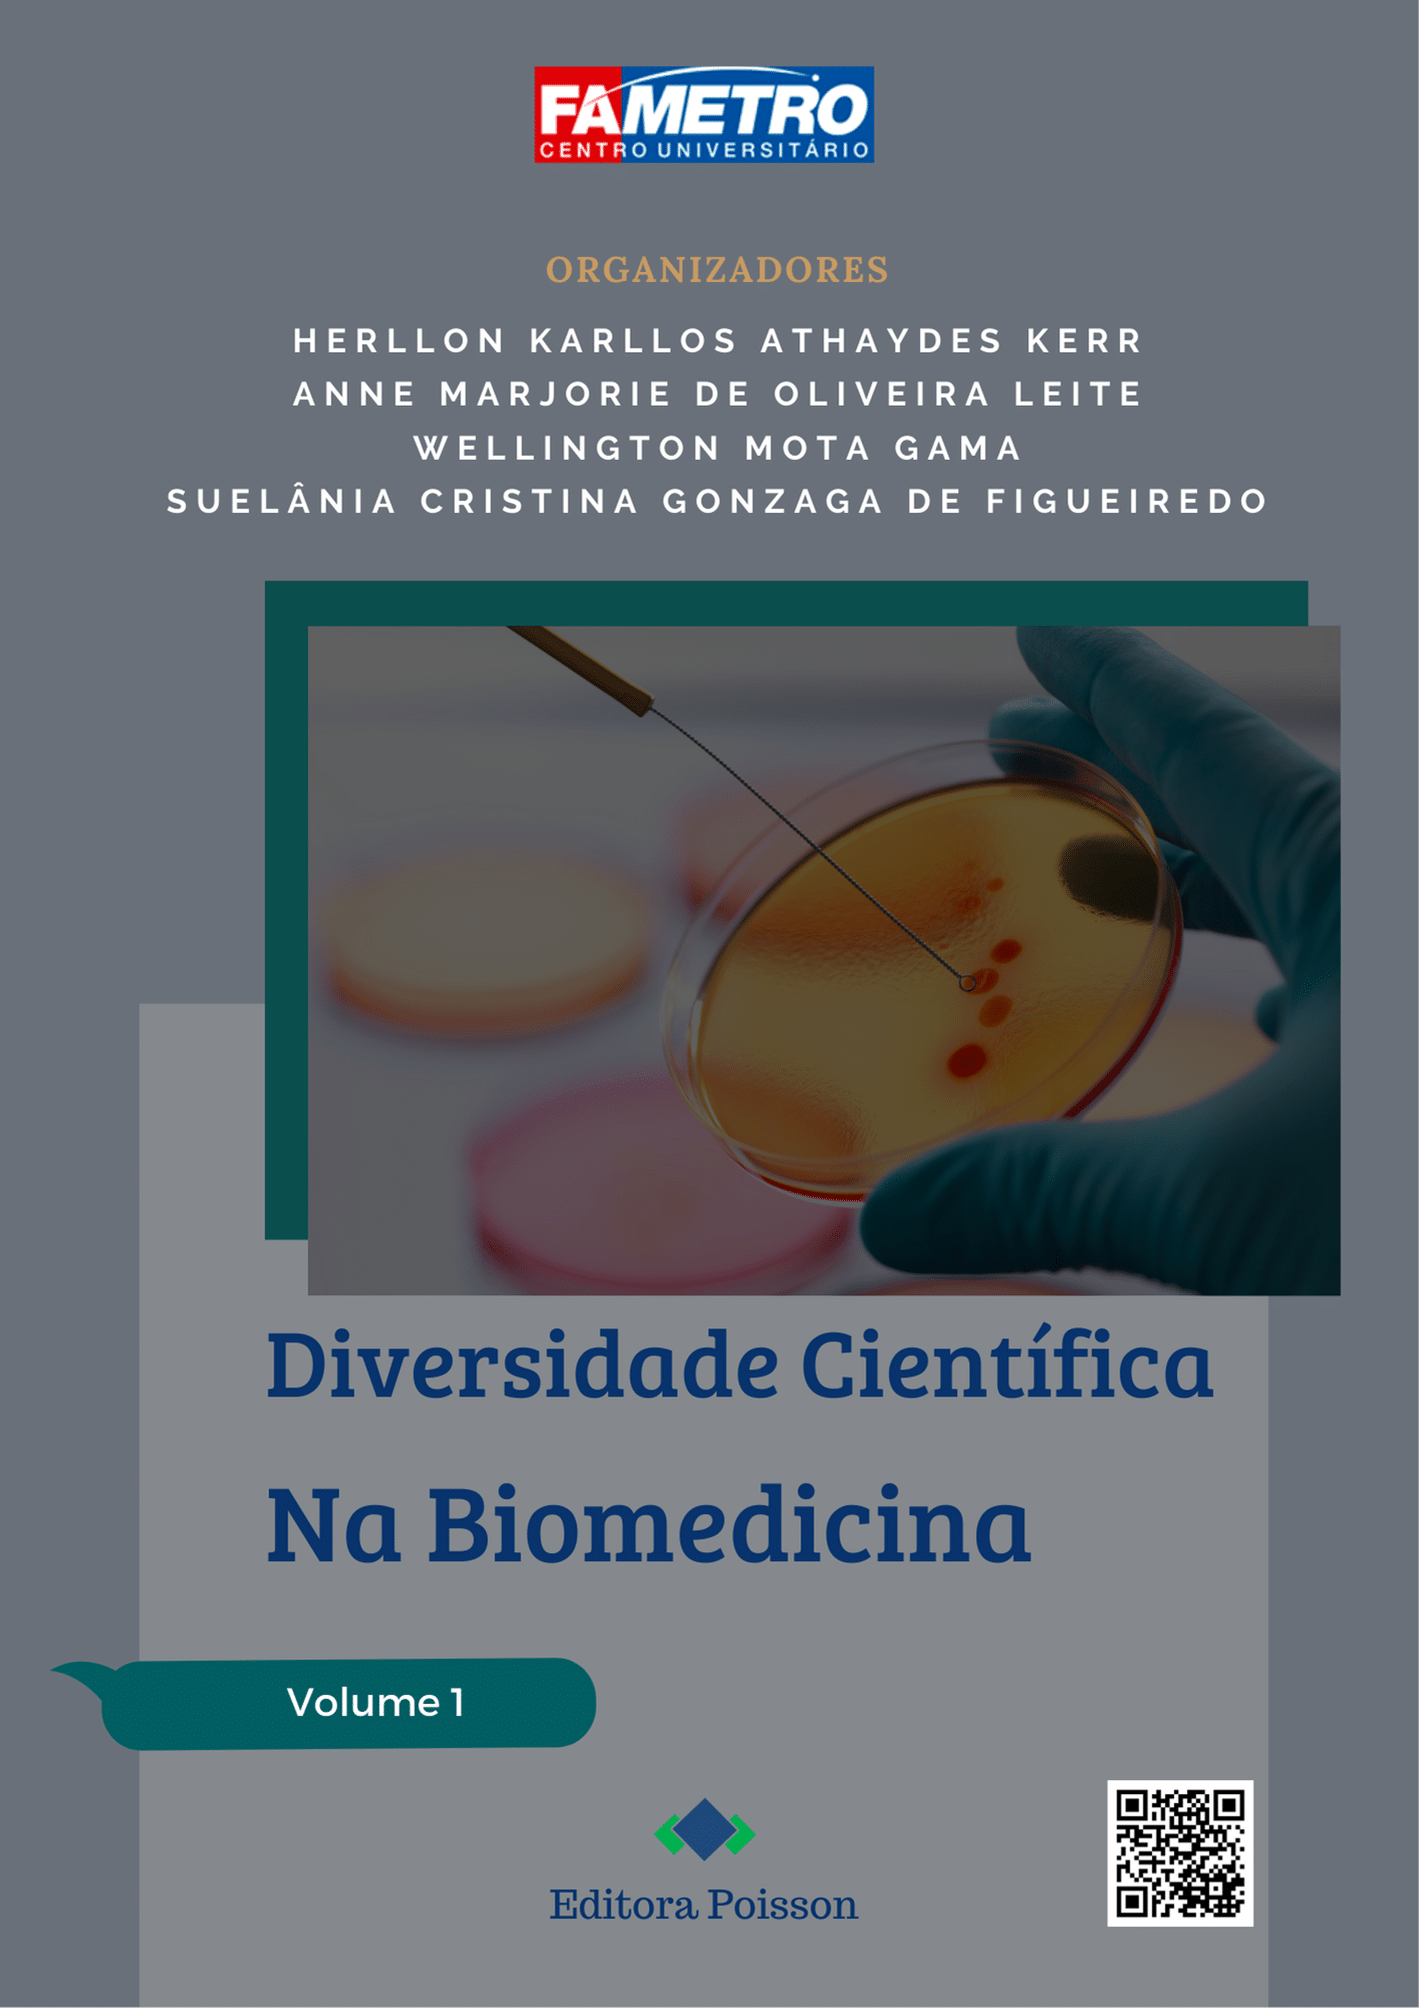

Diversidade Científica na Biomedicina – Volume 1
ISBN
DOI
Descrição
Ler Online
Preencha o formulário abaixo e receberá no seu email o link para baixar o livro.
Conteúdo
Capítulo 1: Desordem dos eventos trombóticos ocasionados pela resposta imune na COVID-19
Breno de Castro Colares, Bárbara Barroso Bulcão Paes, Adriel Nery Rodrigues
DOI: 10.36229/978-65-5866-165-8.CAP.01
Capítulo 2: As principais bactérias causadoras de intoxicações alimentares oriundas de produtos enlatados
Bruna Kellen Fernandes Ximenes, Teylor Abucater De Barros
DOI: 10.36229/978-65-5866-165-8.CAP.02
Capítulo 3: Terapia gênica na hemofilia
Ana Paula Mathias, Catherine Bianca Oliveira do Rego, Eron Carlos Roberto Pinto
DOI: 10.36229/978-65-5866-165-8.CAP.03
Capítulo 4: Resistência bacteriana a antibióticos – pseudonomas aeruginosas
Kemily da Silva Dinelly, Tainá Xavier Lopes
DOI: 10.36229/978-65-5866-165-8.CAP.04
Capítulo 5: Estudo da água potável da bacia do Rio Guandu – RJ – Brasil
Maria Iolanda Monteiro do Nascimento Bandeira, Raquel do Nascimento Bandeira
DOI: 10.36229/978-65-5866-165-8.CAP.05
Capítulo 6: Diagnóstico laboratorial da Leucemia Linfoide Aguda
Isabelly Ferreira Silva, Kallyandra Marly Cunha de Almeida, Lucas Lima de Oliveira
DOI: 10.36229/978-65-5866-165-8.CAP.06
Capítulo 7: A importância do exame de Papanicolau na detecção de lesões precursoras do câncer de colo de útero
Alessandra Yara Souza Articlino, Elibergson de Souza Lima, Karine Souza dos Santos
DOI: 10.36229/978-65-5866-165-8.CAP.07
Capítulo 8: Criopreservação de gametas e embriões
Ana Herlen Maciel Mota, Rayra da Silva Garcez
DOI: 10.36229/978-65-5866-165-8.CAP.08
Capítulo 9: Importância do teste de avidez de IGG para o diagnóstico de fase aguda da toxoplasmose em gestantes
Ciely da Cruz de Melo, Cleiciane Rodrigues da Silva, Josiete Lopes de Alcântara
DOI: 10.36229/978-65-5866-165-8.CAP.09
Capítulo 10: Toxina botulínica: Erros de aplicações e as reações adversas
Ana Caroline Oliveira da Silva, Rebeka Barros Rodrigues
DOI: 10.36229/978-65-5866-165-8.CAP.10
Capítulo 11: Fisiologia de pacientes obesos infectados pelo COVID-19
Rhuany Bruna Guimarães de Medeiros, Samilles Epifânio Farias
DOI: 10.36229/978-65-5866-165-8.CAP.11
Capítulo 12: A implicância da vacinação no controle epidemiológico das meningites bacterianas
Kevyn Gabriel Castelo Branco de Souza, Thamires Bastos Pinheiro
DOI: 10.36229/978-65-5866-165-8.CAP.12
Capítulo 13: A importância do diagnóstico precoce da Anemia Falciforme em crianças
Ana Carolina de Lima Souza, Andreza da Silva Ferreira, Silvany da Silva Moura
DOI: 10.36229/978-65-5866-165-8.CAP.13
Capítulo 14: Parasitose intestinal: A relação do Diphyllobothrium latum como parasita causador da Difilobotríase Humana
Álvaro Silva Souza, Erik Bruno Portela da Silva, Isabelli Nogueira da Matta
DOI: 10.36229/978-65-5866-165-8.CAP.14
Capítulo 15: Atividade da telomerase em melanomas na população negra
Eduardo da Silva Queiroz, Ana Claudina da Costa Monteiro
DOI: 10.36229/978-65-5866-165-8.CAP.15
Capítulo 16: Comparação de técnicas com o uso do PRP (plasma rico em plaquetas) para tratamento estético e preenchimento
Layla Cristinne Aguiar Viana, Carolliny Carvalho da Silva
DOI: 10.36229/978-65-5866-165-8.CAP.16
Capítulo 17: As linhagens da SARS-COV-2 no Amazonas e suas características
Hâmilly Shaielly de Holanda Coelho, João Vitor Silva de Almeida, Lizandra Natasha Paz Barroso
DOI: 10.36229/978-65-5866-165-8.CAP.17
Capítulo 18: Impactos do vírus influenza A (H1N1) na saúde pública no Brasil, no período de 2009 a 2021
Brenda Farias Tavares, Cristiane Lima Magno
DOI: 10.36229/978-65-5866-165-8.CAP.18
Capítulo 19: Bactérias resistentes – Staphylococcus aureus
Fernando Luís Cunha Oliveira da Silva, Francinaldo Alves da Silva, Wallace Faustino da Silva
DOI: 10.36229/978-65-5866-165-8.CAP.19
Capítulo 20: Anemia megaloblástica associada a pacientes submetidos à gastrectomia
Karen Liara Moya de Souza, Maria Julia da Silva Aguiar
DOI: 10.36229/978-65-5866-165-8.CAP.20
Capítulo 21: Relação entre parasitoses e anemias
Lucas Costa Canuto, Mateus Costa Maciel
DOI: 10.36229/978-65-5866-165-8.CAP.21
Capítulo 22: Biomarcadores: Analisando a importância do diagnóstico do Alzheimer pela proteína Tau
Estela Nogueira da Silva, Isabela Prestes Farias, Rondienny Andrade Filgueiras
DOI: 10.36229/978-65-5866-165-8.CAP.22
Capítulo 23: A radiofrequência no rejuvenescimento facial (RF) em mulheres de 25 a 50 anos
Francinete Rodrigues da Silva, Thales Eduardo de Castro, Anaivanessa Ferreira Batista Xisto
DOI: 10.36229/978-65-5866-165-8.CAP.23
Capítulo 24: Os desafios no combate à malária no estado do Amazonas
Douglas Viana Bragança, Fernanda Sampaio da Silva
DOI: 10.36229/978-65-5866-165-8.CAP.24
Capítulo 25: Ozonioterapia como terapia integrativa no tratamento de sequelas e intercorrências pós-cirúrgicas
Ariana Maia Leal, Cecilia Pereira Sales Neta, Raquel Albuquerque dos Reis, Sheila Cristina Torres da Silva Meireles
DOI: 10.36229/978-65-5866-165-8.CAP.25
Veja também esses outros títulos
Produtos relacionados
-

Proposta de diretrizes em planejamento para desempenho de projetos elétricos industriais
Leia mais -

Docência em Foco: Caminhos Formativos em Pedagogia
Leia mais -

Saberes da Engenharia: Uma contribuição para a sociedade – Volume 6
Leia mais -

Cultura corporal em pauta: Ginásticas, Acroyoga e Pole dance
Leia mais